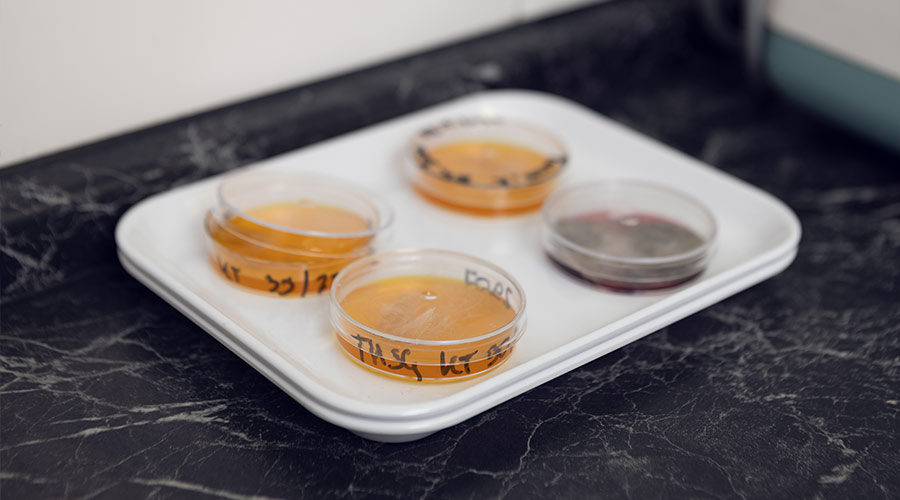
Vier beschriftete Petrischalen auf weißem Tablett, gefüllt mit gelblichem und rötlichem Nährboden, stehend auf schwarzer Oberfläche.

Diagnostik
- Ultraschall
- Röntgen
wir, das heißt die Mitarbeiter der Tierarztpraxis am Flügel, möchten Ihnen hiermit den Service und die tierärztlichen Leistungen unserer Praxis vorstellen.
Unsere Praxis besteht seit dem 01.01.86 und ist seit 01.02.95 eine Gemeinschaftspraxis. Die Praxis ist eine Gemischtpraxis, d.h. dass bei uns Kleintiere (Hund, Katze, Heimtier) und Großtiere (Pferd, Rind, Schaf, Ziege, Schwein) gleichermaßen behandelt werden.
Die nachfolgend näher beschriebenen Diagnostika wenden wir ja nach Bedarf bei Groß- und Kleintieren an.
Sollten Sie noch weitere Fragen haben, wenden Sie sich bitte an ein Mitglied unseres Praxis-Teams.
Wir helfen Ihnen gerne weiter.
Und noch etwas: Haben Sie bitte auch Verständnis, wenn einmal etwas nicht ganz nach Plan läuft. Sie können sicher sein, dass wir alle unser Bestes geben. Wir sind aber alle – trotz der ganzen modernen Hilfsmittel – nur Menschen.

Unsere Sprechzeiten sind:
Montag, Mittwoch und Freitag von 8:00 Uhr - 12:30 Uhr und 13.30 Uhr - 17:00 Uhr
Am Dienstag: 8:00 Uhr - 12:30 Uhr und 13:30 Uhr - 19:00 Uhr
Bitte füllen Sie vor dem ersten Besuch das Neukundenformular aus. Zusätzlich müssen Sie die Datenschutzerklärung abgeben.
Nein! Wildtiere dürfen wir nicht behandeln, auch das Abgeben von Wildtieren ist bei uns verboten. Bitte wenden Sie sich an den Jagdaufseherverband NRW.
Ja, eine Zahlung mit EC-Karte ist möglich.
Gerne verweisen wir bei speziellen Dingen auf unseren Kollegen Dr. Pieper.
Schnabel kürzen und weitere Standarduntersuchungen können bei uns in der Praxis durchgeführt werden.
JA! Man benötigt einen Termin, um unsere Praxis besuchen zu können.
Pauschal kann man nicht sagen, was eine Behandlung kostet. Dies hängt von vielen Möglichkeiten ab.
Ja, wir behandeln auch Hühner bei uns in der Praxis.